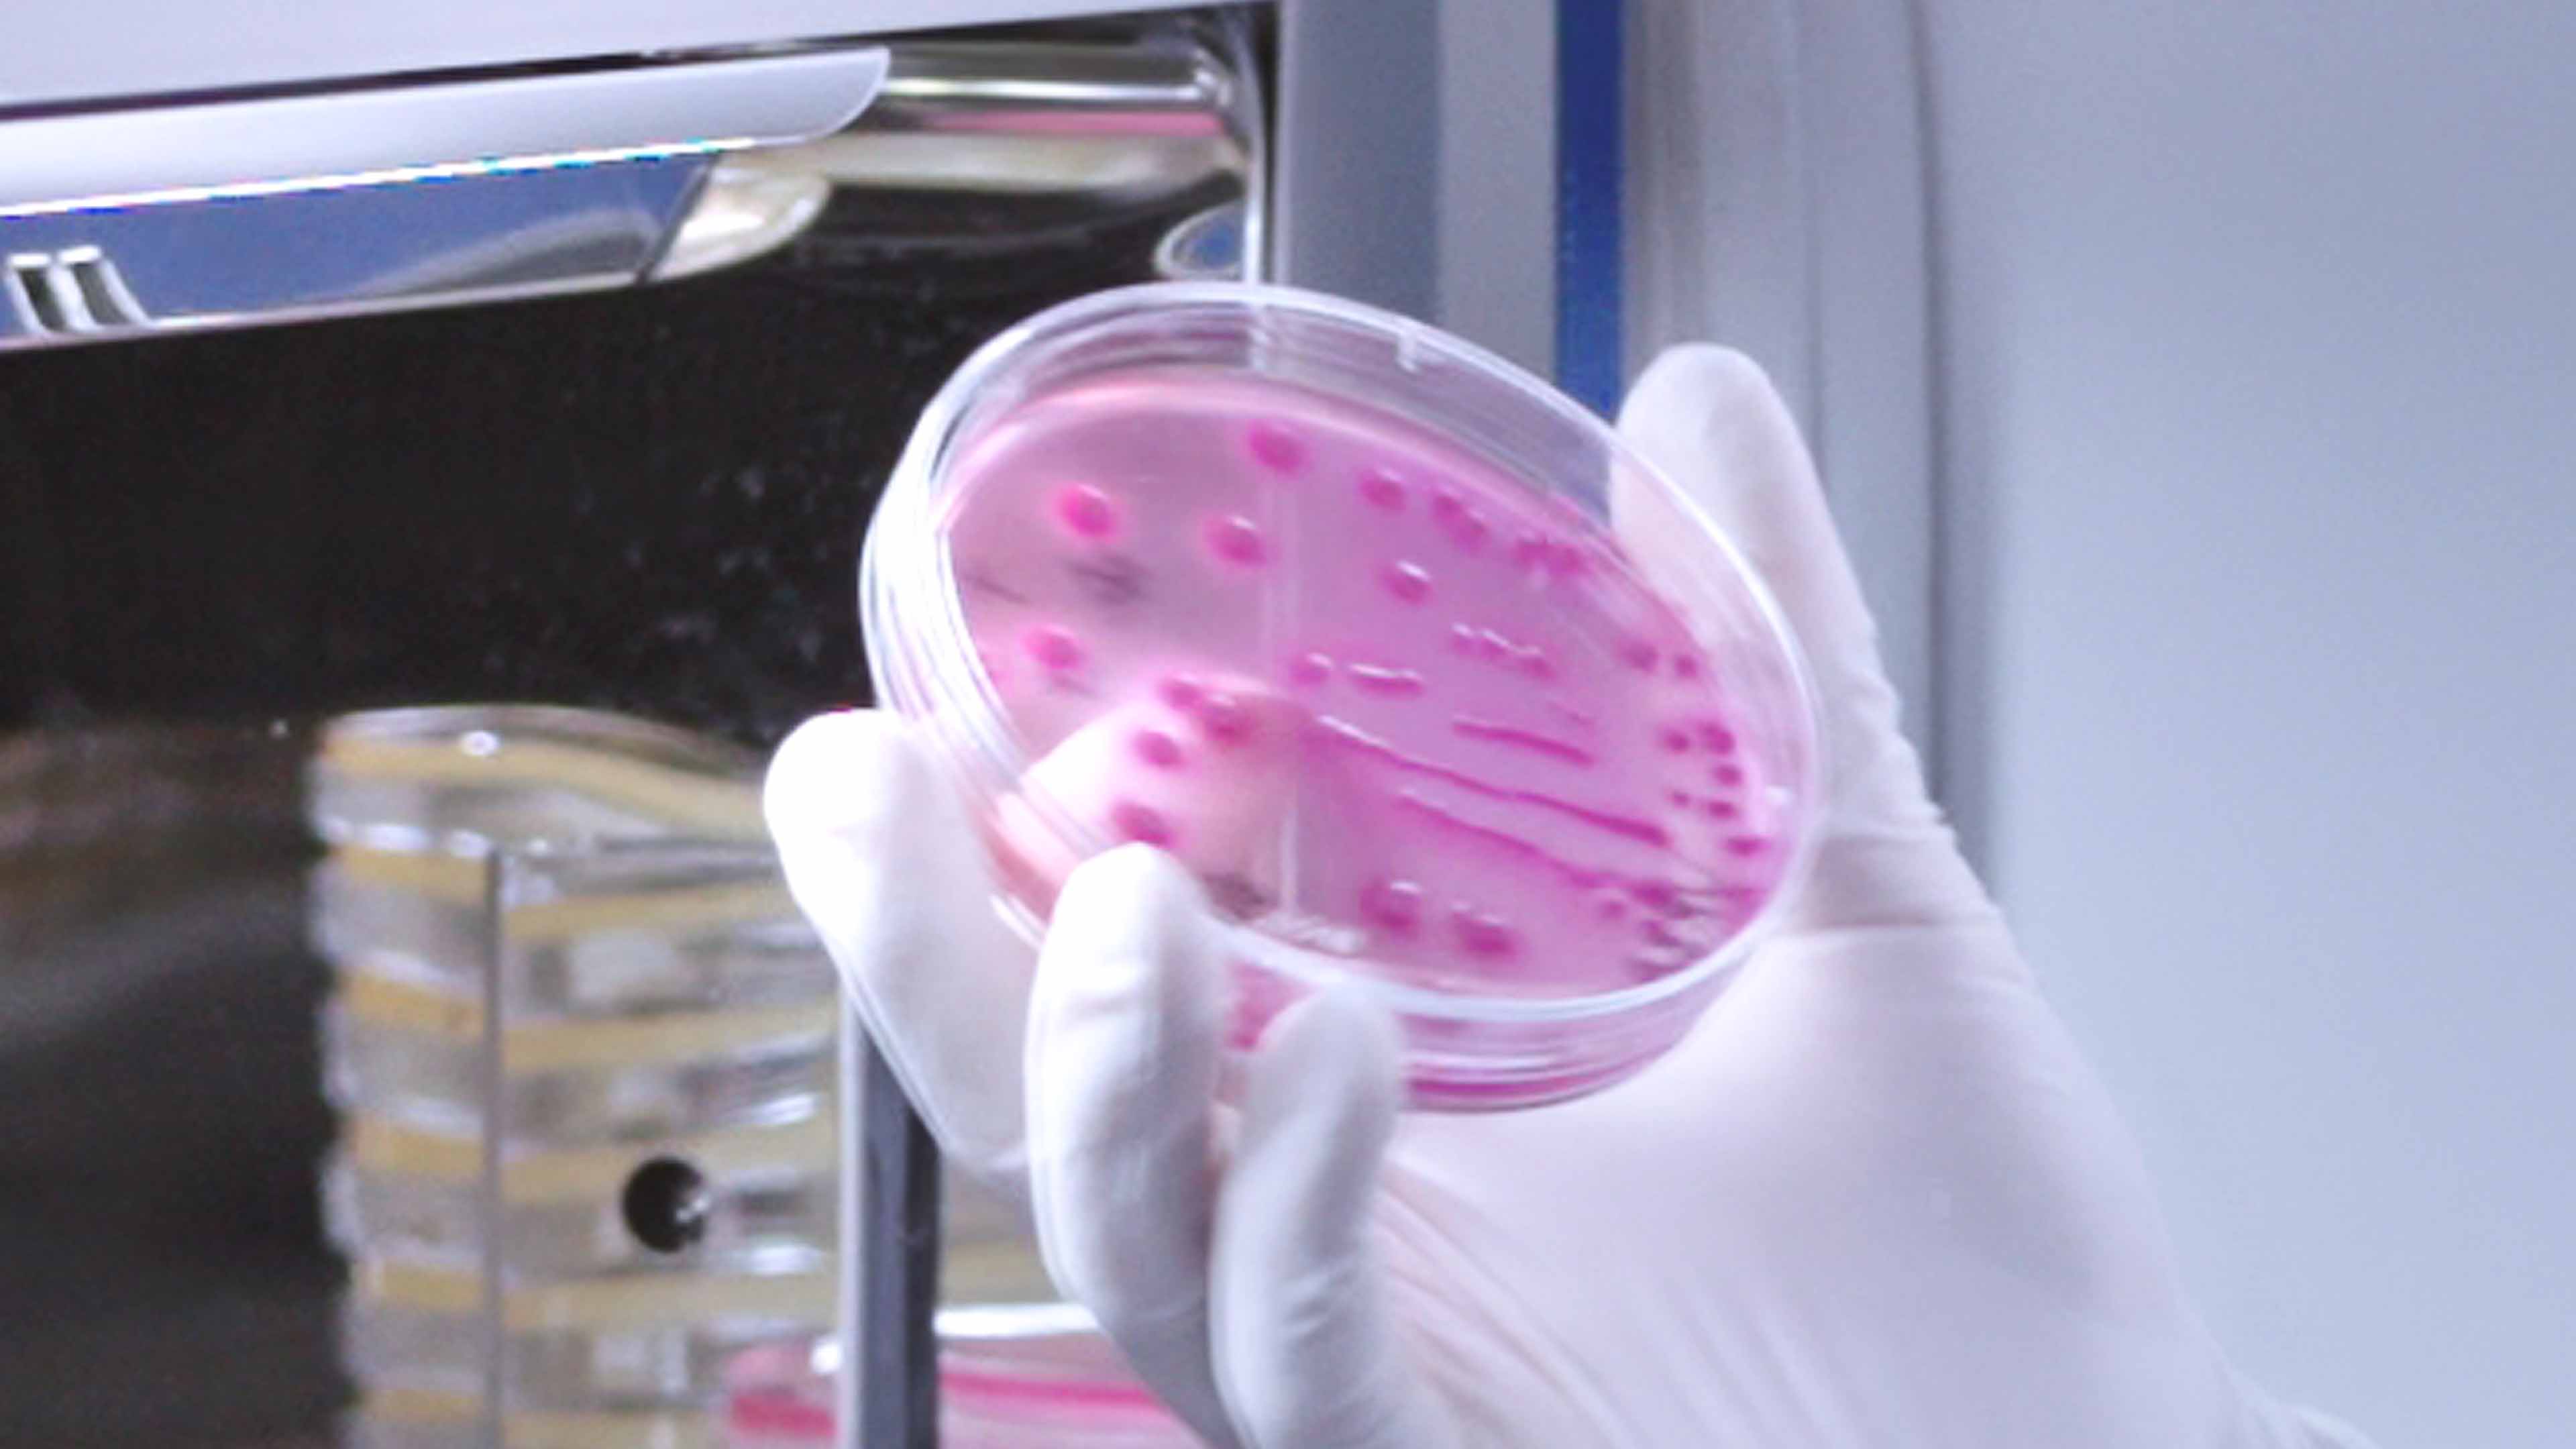

水煮花生的防腐剂误区:苯甲酸为什么不能随便加?
2026-05-16
查看更多

别再被误导了!吃水果≠吃果糖
2026-05-13
查看更多

春游野餐怎么吃才安全?这份避坑指南请收好!
2026-05-09
查看更多

蜂蜜结晶了,是坏了还是变质了?
2026-05-06
查看更多

聊聊茶叶过度包装的问题
2026-04-30
查看更多

你家筷子用多久了?发霉的筷子有多危险?
2026-04-29
查看更多

蓝莓吃对才安心,来自检测机构的小提醒
2026-04-25
查看更多

水果越来越甜,是打了甜蜜素?
2026-04-22
查看更多

两批花生油被通报!过氧化值和酸价超标!
2026-04-16
查看更多

溴酸盐超标,你喝的水安全吗?
2026-04-15
查看更多

鱼片里的寄生虫,到底怎么防?
2026-04-13
查看更多

吐司面包被通报!过氧化值超标
2026-04-08
查看更多

私人秘制的人参酒,你敢喝吗?
2026-04-04
查看更多

央视曝光!你吃的活鱼,可能被麻醉过?
2026-04-01
查看更多

牛奶保质期越长,添加剂越多?真相来了
2026-03-28
查看更多

清明的甘蔗 —— 这份春日甜蜜,你真的会挑吗?
2026-03-25
查看更多

检测机构的春日预警
2026-03-21
查看更多

漂白鸡爪上热搜:我们还要警惕这些
2026-03-18
查看更多

绿豆汤,肠胃弱到底能不能喝?
2026-03-14
查看更多

100% 果汁里怎么还有水?食品标签的真相
2026-03-11
查看更多

汤圆里被加工业胶不能吃?我们把真相说清楚
2026-03-06
查看更多

剩菜只要保存好,就能吃一周?
2026-03-04
查看更多

以案说法|你爱吃的砂糖橘,真的安全吗?
2026-02-28
查看更多

春季这口“鲜”可能暗藏风险——贝类水产品食用安全提示
2026-02-25
查看更多

骏马奔腾迎新春,托斯特检测贺佳节
2026-02-16
查看更多

肉丸鱼丸禁止添加……
2026-02-11
查看更多

破除饮食误区:高胆固醇者,不能吃蛋黄?
2026-02-08
查看更多

网购“鲜百合”煮汤竟致全家中毒?这种“毒物”你可能也买错过!
2026-02-04
查看更多

速冻水饺,真是“垃圾食品”吗?
2026-01-31
查看更多

维C含量竟是苹果10倍?被小看的土豆
2026-01-28
查看更多

蔬菜榨成汁会更健康?
2026-01-24
查看更多

阴凉干燥处,到底是多少度?
2026-01-21
查看更多

自来水有“消毒水味”,泡茶能解决吗?
2026-01-17
查看更多

寒冬“食黑”有讲究,科学进补看检测
2026-01-14
查看更多

托斯特检测小科普:沙姜里的藏着铅隐患?
2026-01-11
查看更多

豆皮也会重金属超标?豆制品安全的科普指南
2026-01-08
查看更多

车厘子:我们该如何理性看待?
2026-01-04
查看更多

守护舌尖安全,探索科学真相——广东海洋大学阳江校区学子走进TOST食品检测认知之旅
2025-12-31
查看更多

市人大常委会到阳东区开展集中视察活动
2025-12-27
查看更多

托斯特检测小科普:草莓农残会致癌?别慌!!
2025-12-24
查看更多

核桃酥不只是甜食!它的蛋白质藏着这些健康小秘密
2025-12-20
查看更多

早上吃的预制面包,你真的了解它吗?
2025-12-17
查看更多

孜然粉:生活里的调味常客,安全防护不能少
2025-12-14
查看更多

食品营养成分检测:让日常饮食更懂健康
2025-12-10
查看更多

冷冻牛肉被查出兽药超标?
2025-12-06
查看更多

托斯特检测小科普:猕猴桃保鲜不用愁!第三方检测来教你
2025-12-02
查看更多

严谨检测守护安全,爱心行动播撒希望
2025-11-29
查看更多

赋能食安监管 彰显专业担当
2025-11-27
查看更多

甜蜜陷阱?关于蜂蜜你必须知道的真相
2025-11-26
查看更多

校企携手筑平台 产教融合育新才
2025-11-22
查看更多

身边的东西细菌多不多?看菌落总数
2025-11-18
查看更多

质量感官鉴别:用 “五官” 守护食品与水质安全
2025-11-15
查看更多

托斯特检测小科普:别再冤枉面条!没营养其实是你吃错了
2025-11-13
查看更多

你常吃的这些食物里,可能藏着赭曲霉毒素!
2025-11-08
查看更多

看不见的威胁,藏在日常饮用水里
2025-11-05
查看更多

天冷吃丸子担心不健康?这份安全报告请查收!
2025-10-30
查看更多

反季节水果打了很多农药?美味背后的健康隐患
2025-10-29
查看更多

托斯特检测小科普:冰箱不是“保险箱”!第三方检测视角下的食物储存真相
2025-10-24
查看更多

不同地方的腊鸭,安全注意点不一样!
2025-10-22
查看更多

托斯特检测小科普:土鸡蛋 vs 普通鸡蛋,兽药使用不是 “谁好谁坏”,关键看这几点
2025-10-16
查看更多

金秋吃蟹不慌!第三方检测为大闸蟹安全把关
2025-10-14
查看更多

科技赋能产业升级 标准引领腊味未来
2025-10-13
查看更多

吃虾必看!科学识别风险+专业检测=安心美味
2025-10-09
查看更多

食安专家说食安|关于“饮用水”知识,你知道多少?
2025-10-08
查看更多

托斯特检测小科普:隔夜菜到底能不能吃?别纠结!这3个知识点帮你避坑
2025-09-30
查看更多

中秋食安预警:月饼质量检测要点与送检指南
2025-09-29
查看更多

关于发布《食品安全国家标准 食品中污染物限量》(GB 2762-2025)等32项食品安全国家标准和2项修改单的公告(2025年 第6号)
2025-09-27
查看更多

托斯特检测小科普:食用油里藏着“隐形杀手”?3招辨优劣,专业检测护健康
2025-09-25
查看更多

秋分时节:从节气养生到食品安全检测的科学守护
2025-09-23
查看更多

贵州“三明治”糕点疑中毒事件敲响食品安全警钟:专业检测机构为您保驾护航
2025-09-22
查看更多

凉菜里藏着“窜稀元凶”!家庭拌凉菜做好这 6 件事,别让肠胃遭罪
2025-09-19
查看更多

托斯特检测小科普:大米里藏着看不见的菌?3招辨异常,专业检测更放心
2025-09-17
查看更多
警惕!这种细菌让全球每年超 1 亿人 “中招”,你家餐桌可能也有!
2025-09-12
查看更多

托斯特检测小科普:你家的自来水安全吗?简单几招教你判断!
2025-09-10
查看更多

新企联走访促交流 共绘乡村振兴新图景
2025-09-06
查看更多

托斯特检测小科普:菜市场的蔬菜,怎么知道有没有农残?
2025-09-04
查看更多

观看抗战胜利80周年阅兵,汲取奋进力量
2025-09-03
查看更多

喜讯|TOST托斯特检测正式获得CMA资质认定 跻身国家认可第三方检测机构行列
2025-07-25
查看更多

广东托斯特检测技术服务有限公司盛大揭牌,开启检测服务新篇章
2025-02-18
查看更多

为什么车厘子历经一个月到中国还不坏?买回家没几天就坏了?
2025-01-24
查看更多

这种饮料让肾病风险增加45%!喝水记住一个原则,很多人不知道!!
2025-01-07
查看更多

最新研究发现“砂糖橘不能再吃了”?真相……
2025-01-05
查看更多

预制菜国标来了!你还担心预制菜吗?
2025-01-05
查看更多
